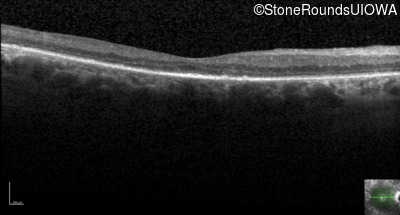
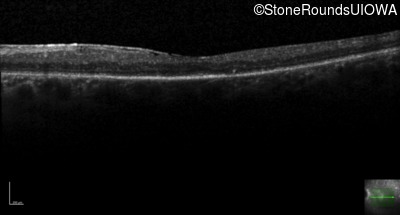
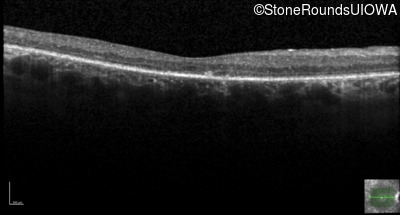
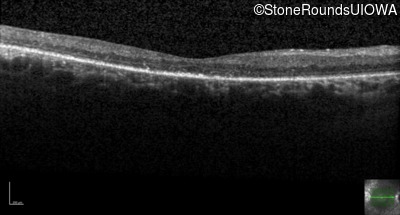
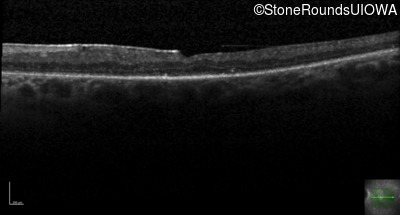
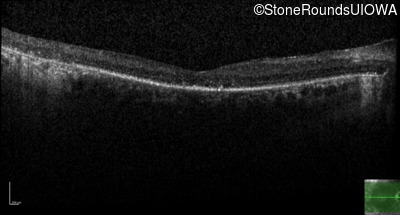
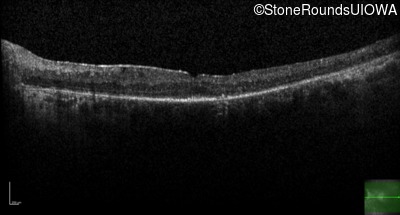
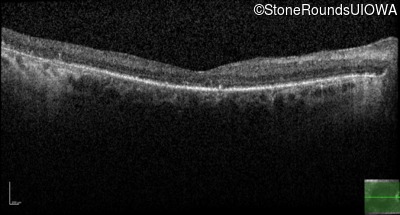
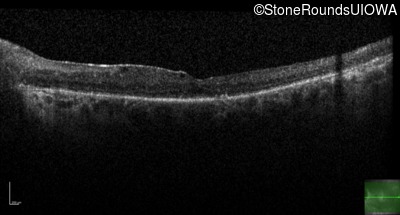
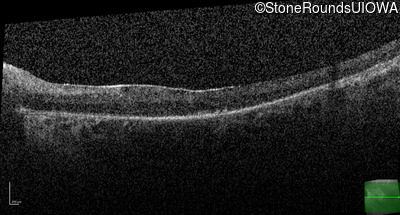
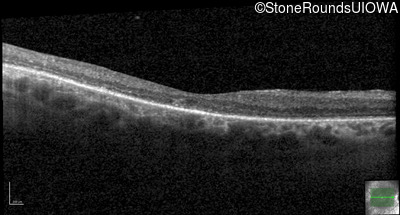
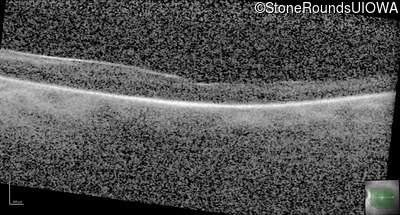
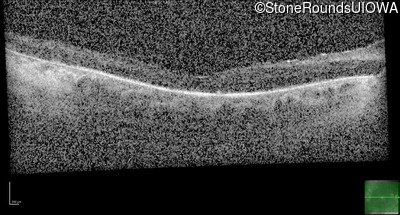
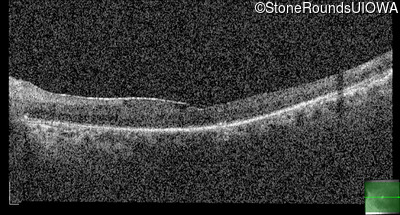
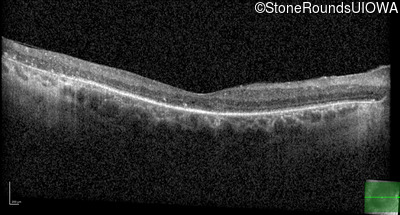
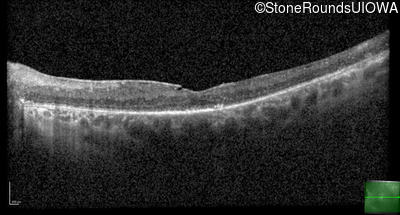

Case
SR854
Student Mode
AD Retinitis Pigmentosa (IA1aii)
Male
Male
Hidden
SR854
Student Mode
AD Retinitis Pigmentosa (IA1aii)
Male
Male
History
This 59 year old man's mother noticed that he did not see well in dim light when he was 3 years old. By age 20 he had fairly significant constriction of his visual fields.
| Age at visit: 28 years |
| OD | OS | ||
|---|---|---|---|
| Age at visit: 33 years |
| OD | OS | ||
|---|---|---|---|
| Age at visit: 59 years |
| Age at visit: 60 years |
| Age at visit: 63 years |
| Age at visit: 65 years |
| Age at visit: 66 years |
| Age at visit: 68 years |
| Age at visit: 69 years (Visit 2) |
Diagnosis & molecular findings
| Disease | Gene | Allele 1 variant(s) | Allele 2 variant(s) | Inheritance mode |
|---|---|---|---|---|
| AD Retinitis Pigmentosa | PRPF8 | Thr1931Met ACG>ATG | AD |